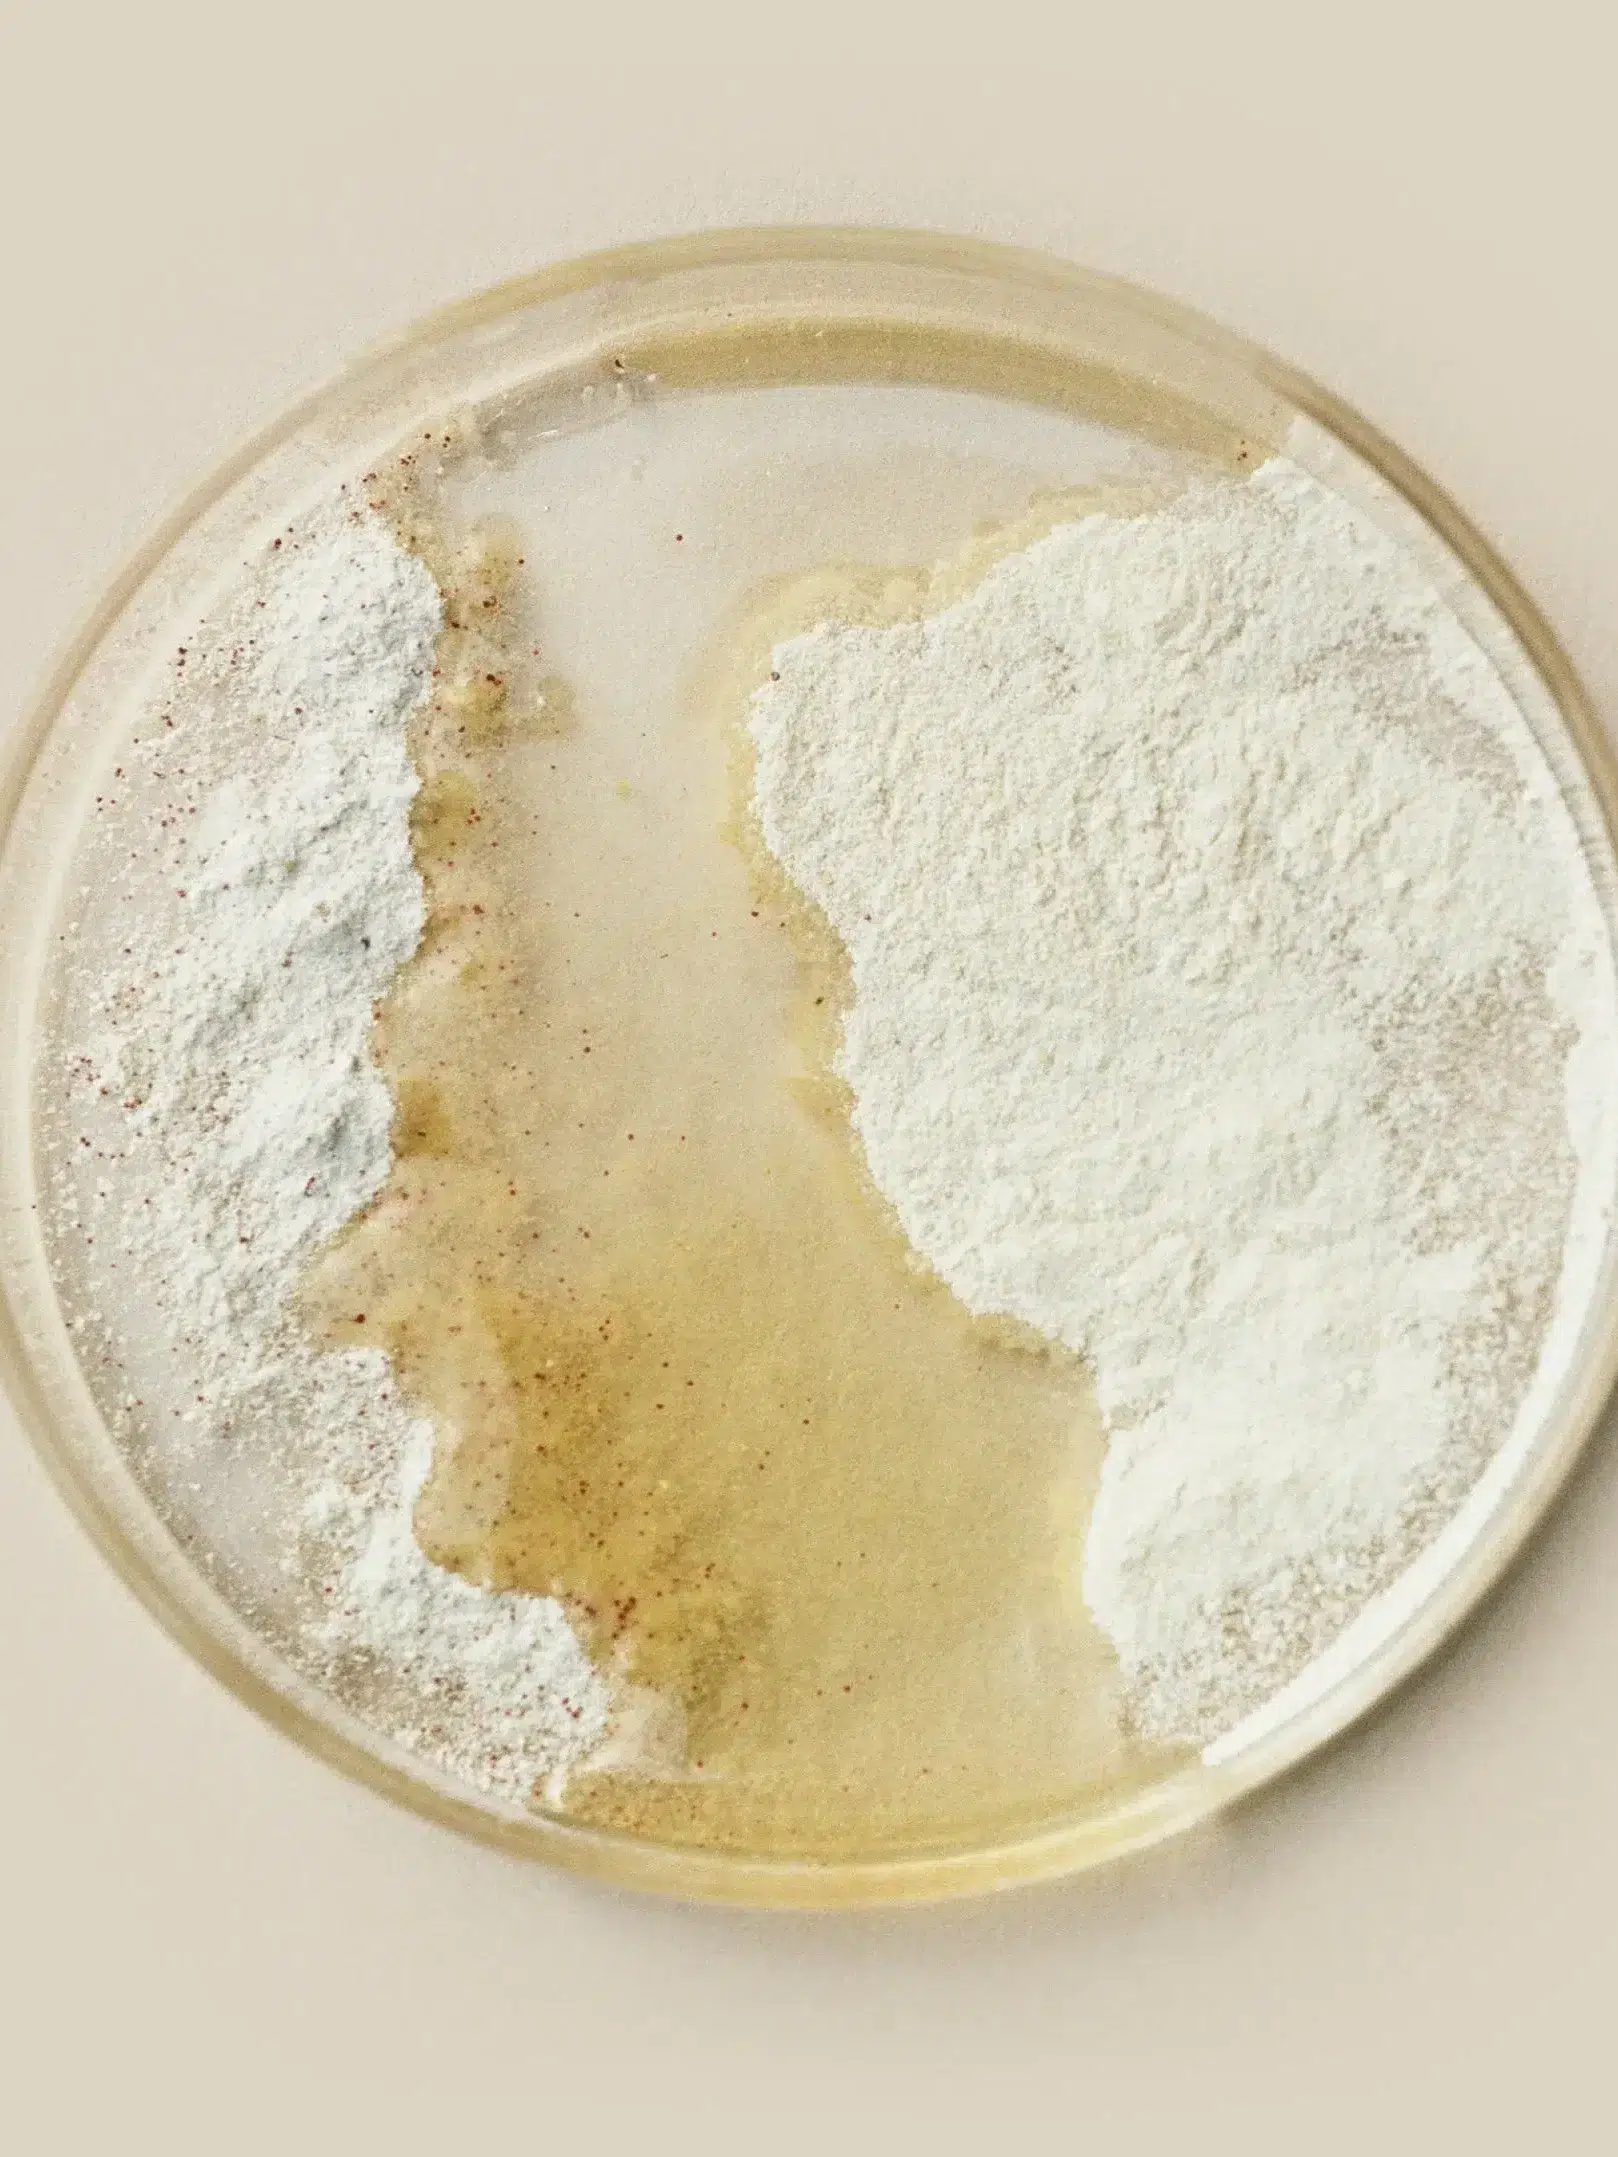
A petri dish contains a mixture of white powder and a yellowish liquid on a beige background.

7 Best Supplements To Ease Bloating
The Good Trade editors endorse products we’ve personally researched, tested, and genuinely love. Learn more about our methodology and business model here.
We’ve personally used and researched the best supplements for bloating relief — these are our top picks that have clean ingredients, work quickly, and are affordable, too.
Is it just us, or does it seem bloating has become a more common (or perhaps more talked about) problem in recent years? Whether the bloat is from food sensitivities, hormonal imbalances, illness, or menstrual-related, having bloat is a serious downer. It’s uncomfortable and even painful at times; plus, it can be a huge bummer when our everyday clothes suddenly don’t fit. All in all, when we have bloat, we want relief. And instantly.
What causes bloating?
Plainly put, bloating is when there is swelling or a feeling of “fullness” in the abdomen. According to Medical News Today, abdominal bloating is common and most often caused by a buildup of gas in the stomach and intestines. It’s generally not a concern when it’s caused by food (hello, Thanksgiving) or goes away in a few days. Of course, it’s always a good idea to talk with your doctor if you have concerns or pain. Digestive enzymes and probiotics can also help, and we love the brands and supplement options below for their efficacy and quick relief.
Our criteria:
Our editors have tested, researched, and read thousands of reviews to determine the best supplements for bloating relief. All of these brands use clean and quality ingredients and have certifications to back up their claims. We frequently update this list with new favorites that meet our criteria below.
- EFFICACY | We want something that works, and these brands are tried and trusted by thousands of customers (and also our editors!).
- CLEAN INGREDIENTS | These brands prioritize clean, high-quality ingredients that are organic, nontoxic, and healthy for our bodies.
- PRICE | We’ve included brands at a range of price points and love that the options below are accessible on various online platforms and websites.
For even more relief, try one of these natural probiotics.
1. Seed
Best For | A synbiotic with 24 strains
Clean Ingredients | Vegan; free from gluten, dairy, soy, nut, shellfish, corn, and sesame; glyphosate/AMPA-free, no binders or preservatives; prop-65 compliant
Price | $50/one month supply
At the top of our list is a brand you’ve likely heard of! We love Seed’s Synbiotic for all things digestion and bloating relief, especially if you’re after a supplement with some serious research backing and certifications. Seed’s probiotic includes 24 clinically studied strains to support whole-body health beyond just your gut. It’s engineered to survive acid, enzymes, moisture, and heat, and the formula has been tested for more than 400 allergens and pesticide residues. Talk about clean! We love that you can sign up for a monthly subscription (free shipping), so you’ll never run out!
Customer Review | “I felt really good throughout the day. I became regular. In about two weeks after taking it, I wasn’t bloated.” – Cameron B. (Read more reviews)


2. Needed
Best For | A supplement with 14 clinically-backed digestive enzymes
Natural & Organic Ingredients | Vegan; free of allergens, GMOs, gluten, and fillers
Price | $45 for a 30-day supply (discounted subscriptions available)
Needed is one of our editors’ favorite brands for all things supplements and wellness. The comprehensive daily Digestive Enzymes supports nutrient absorption, digestive comfort, overall gut health, energy, immunity, and more. Since modern food processing depletes our food of naturally occurring enzymes (we need enzymes to help break down what we’re eating and support digestion!), this supplement aids in optimal digestion so our body can better process and absorb proteins, carbohydrates, fats, as well as sensitive foods like dairy, gluten, and legumes. Also, this supplement is pregnancy-safe!
Customer Review | “I took this pill before having brunch with bread and cheese. I am gluten and dairy sensitive, so this pill helped me not have bloat or gas pains after eating the brunch I had. I will continue to use the product especially when I’m out dining and unable to avoid my sensitivities..” (Read more reviews.)


3. AG1
Best For | Powder supplement
Clean Ingredients | Vegan; organic ingredients; non-GMO; free of fillers & preservatives; free from gluten, corn, eggs, peanuts, dairy, & animal by-products
Price | $99/one month supply; discounted subscriptions available (20%+ off)
Known formerly as Athletic Greens, AG1 is an excellent option if you’re looking for bloat relief in powder form. We love that this option knocks out a few birds with one stone, too, since the formula has daily greens, added vitamins and nutrients, as well as pre-and probiotics. It also includes nutrient-dense extracts, herbs, antioxidants, digestive enzymes, phytonutrients, and multi-minerals. As for the taste? It’s been editor-tested and approved! The powder mixes easily into a morning smoothie or water (the flavor is a bit citrusy).
Our Editor’s Review | “As for the claims about feeling better: AG1 actually works. After 30 days with the supplement, I felt more energized and less bloated” – Kayti Christian, Senior Content Strategist [Read our full review.]


4. Love Wellness
Best For | Combo of digestive enzymes and botanicals
Clean Ingredients | 6 critical digestive enzymes, no sugar, ingredient purity testing, free of gluten and dairy
Prices | $25/one month supply (discounted subscription rates up to 50% off)
There is so much to love about Love Wellness, including its powerful bloat-relief supplement, Bye Bye Bloat. Formulated to alleviate hormonal and food-related bloating gently, this supplement is clinically proven to be fast-acting and provide quick relief via healthy digestion. We love that it significantly helps with supporting gluten and dairy digestion and has undergone rigorous third-party testing for ingredient purity. Plus, the colorful bottles are just so cute on our countertop!
Customer Review | “I feel like my stomach is so much flatter when I use ByeBye Bloat consistently! I am so glad I gave this a try and will definitely be a repeat customer.” – Elizabeth (Read more reviews.)


5. Perelel
Best For | Doctor-formulated bloat relief
Clean Ingredients | Free of soy, gluten, and dairy; non-GMO
Price | $35/one month supply; discounted subscriptions available
Get bloat relief with this potent botanical blend from Perelel, a leading company in researched-back and doctor-formulated supplements. Whether you have an upset stomach, need digestion support, or want to relieve gas, this small but mighty capsule keeps things moving, if you know what we mean. A few of the organic extracts include ginger root, fennel seed, and lemon balm. Everything from Perelel is third-party tested and made in the USA. Read more about the brand’s rigorous standards here.
Customer Review | “I have been using Bloat Relief daily this past month and I have noticed such a difference!! I have had a problem with my digestion and feeling so bloated after anything I would eat! I feel ten times better and it’s absolutely been helping with my digestion. This is a 10/10.” – Michelle (Read more reviews.)

6. Hilma
Best For | Budget-friendly relief
Clean Ingredients | Clean Label Project™ certified, vegan, non-GMO, free of gluten and soy; no synthetic colors, fillers, dyes, sweeteners, or flavors.
Price | $10/28-count (discounted subscriptions available)
Hilma Gas + Bloat Relief is so affordable and offers us instant comfort and digestive support. Created by a board of doctors, PhDs, and herbalists, it uses five natural ingredients to calm the GI tract and break up gas. You can trust Hilma to be kind to your wallet and body: it’s formulated without drugs, dyes, fillers, or added sugars. We keep a bottle in our purse at all times for quick relief after a meal out.
Customer Review | “I take two when I’m ridiculously bloated & a half hour later I’m depuffed! Works great for me, thank goodness.” – Jilly (Read more reviews.)


7. The Nue Co
Best For | Bloat relief with immunity and gut health support
Clean Ingredients | Vegan, non-GMO, traceable and tested ingredients, anti-inflammatory
Prices Starting At | $50/one-month supply (discounted subscriptions available)
The Nue Co’s Debloat+ has over 500 reviews and is one of our favorite supplements for easing bloating, improving gut health, and supporting immunity. It calms chronic bloating fast with a proprietary blend of digestive enzymes, clinically studied actives, and anti-inflammatory ingredients used for centuries in Ayurvedic medicine to treat gastrointestinal issues. In clinical trials, 51% of people reported a reduction in bloating, nausea, gas, and abdominal fullness within 30 days of taking this daily.
Customer Review | “I’ve been using this when I have overeaten or had too much rich food, and it really works – no stomachache, less bloat and gas.” – Kendel (Read more reviews.)


Kayti Christian is a Contributing Editor at The Good Trade. She has a Master’s in Nonfiction Writing from the University of London and is the creator of Feelings Not Aside, a newsletter for sensitive people.